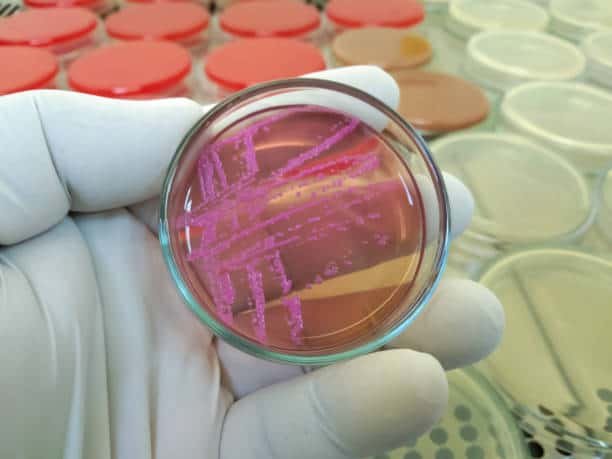

Description
What is a stool culture and sensitivity test?
Test Overview
A stool culture is a test on a stool sample to find germs (such as bacteria or a fungus) that can cause an infection. A sample of stool is added to a substance that promotes the growth of germs. If no germs grow, the culture is negative. If germs that can cause infection grow, the culture is positive.
What does a stool culture diagnose?
A stool culture is used to detect the presence of disease-causing (pathogenic) bacteria and help diagnose an infection of the digestive system (gastrointestinal, GI tract).
What is the significance of the negative stool culture and sensitivity test?
Normal results are negative. This means that no abnormal bacteria or other organisms were found in your stool culture and that you don’t have an infection. Positive results mean bacteria, parasites, or other abnormal organisms were found in your stool culture. They may be causing your infection.

Reviews
There are no reviews yet.